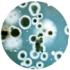
SE-PAT-Hongos_100x100-8

NOSOTROS
Brindamos un servicio de alta calidad con productos efectivos y personal especializado para cuidar de usted, su familia y el medio ambiente.
Con SEICOP VIVE SIN PLAGAS

BENEFICIOS
Experiencia
De más de 35 años en campo y 23 años en Quintana Roo
Normas Mexicanas que nos regulan.
COFEPRIS
NOM-256-SSA1-2012
NOM-018-STPS-2015
NMX-F610-NORMEX-2002
Personal capacitado
Personal capacitado para cumplir con el servicio que solicites.
NUESTROS SERVICIOS
Ofrecemos acciones para prevenir, controlar, excluir, reubicar, y eliminar según sea la necesidad del problema.
Servicios Básicos

Control de insectos
rastreros
Cucarachas
Arañas
Hormigas
Alacranes

Control de insectos
voladores
Moscas
Mosquitos
Tábanos

Control de
roedores
Ratas
Ratones
Tuzas

Control de plagas
de jardin
Gallina ciega
Nematodos
Pulgones
Escamas
Mosquita blanca

Control de insectos
rastreros
Cucarachas
Arañas
Hormigas
Alacranes

Control de insectos
voladores
Moscas
Mosquitos
Tábanos
Servicios Especializados

Control de plagas en
granos almacenados
Palomillas
Carcomas
Gorgojos
Picudos

Control de
microorganismos
Psócidos
Ácaros

Control de insectos de temporada
Ciempiés
Cochinillas
Alacranes

Control de insectos hematófogos
Pulgas
Garrapatas
Chinches

Badge Text

Servicios contra
termitas
Subterránea
Madera seca
Desinfección de
patógenos
Virus
Bacterias
Hongos

Reubicación de organismos ocasionales
Serpientes
Murciélagos
Aves
Abejas
Tejones
Mapache
PROMOCIONES
Se acercan los calores y con ello las plagas🪳🦂 🐜 🐀.

Has tu servicio para proteger tu casa o negocio. 15% de descuento en el mes de Marzo
INTEGRAMOS MÉTODOS Y ESTRATEGIAS
- Control Cultural: Asesoría al cliente para mejoría interna de sus deficiencias estructurales y de saneamiento.
- Control Mecánico: Uso de dispositivos equipos y accesorios trampas de captura y monitoreo de plagas.
- Control Físico: Modificación de temperaturas en los entornos considerando calor, frio etc.
- Control Químico: Uso de insecticidas de alta efectividad y mínimo riesgo a las personas y de rápida degradación en el medio ambiente y es nuestra ultima alternativa de control.
TRABAJOS DE DESINFECCIÓN
Algunos de nuestros trabajos de desinfección.






NUESTROS DISTINTIVOS
Autorizados por la COFEPRIS con la Licencia Sanitaria Federal No. 016 AP 23008 2012 .










CLIENTES SATISFECHOS
COTIZA TU SERVICIO
Nuestro equipo de atención a clientes esta para ayudarte a tomar la mejor elección para ti o tu empresa.

